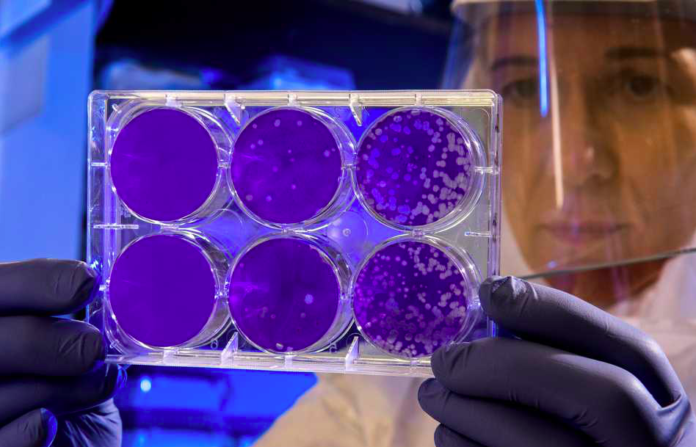

Mentre la curva dei contagi in Italia rimane costate o al massimo aumenta di giorno in giorno, una ricerca messa in pratica dalla fondazione Gates dell’Università di Washington, spiega come sia rimasto davvero poco tempo prima che il sistema sanitario italiano arrivi ad un collasso definitivo.
Secondo i ricercatori statunitensi, se il ritmo dei contagi giornalieri dovesse essere il medesimo, il 10 novembre i posti letto occupati all’interno degli ospedali italiani toccherebbero quota 32mila, che corrisponde alla cifra record toccata dal nostro paese nei tragici periodi tra marzo e aprile.Â
Da questa analisi è facile dedurre come nei 14 giorni successivi al 10 novembre si possa arrivare a quota 75mila ricoveri, ovvero il 40% dei posti letto disponibili in Italia. Sarebbe questo il picco che l’attuale governo vorrebbe evitare di raggiungere, non a caso l’esecutivo negli ultimi giorni ha più volte ribadito di avere solamente 20 giorni di tempo per evitare che il sistema sanitario giunga ad un collasso definitivo e che di conseguenza quest’ultimo non sia più in grado di poter fornire aiuto o soccorso a coloro che ne avranno bisogno.
Sempre secondo la ricerca della fondazione Gates, a Roma circa il 40% delle telefonate al 118 riguarda solo degli eventuali sospetti di contagi legati al Covid, mentre per quanto riguarda Milano, tale cifra raggiunge il 75%. Tutto ciò deriva dal fatto che, vista la situazione di allarme, anche chi ha una banale febbre a 38 alza la cornetta. L’istituto stima che entro il 24 novembre i posti letto occupati in terapia intensiva toccheranno quota 6.600 (fino a ieri erano 1843).
Secondo i ricercatori statunitensi, la problematica principale è data dal fatto che nel momento in cui un paziente che ha contratto il Covid-19 giunge in ambulanza presso l’ospedale, spesso e volentieri è costretto ad aspettare a bordo del mezzo di soccorso anche per 24 ore prima che gli venga trovato un posto letto. Una questione di grande rilevanza che porta il caos non solo all’interno degli ospedali, ma anche all’esterno. Del resto basta considerare che molte strutture sanitarie sono dotate addirittura di 30 o 50 ambulanze per provare anche solo ad immaginare cosa potrebbe accadere e cosa, in parte, sta già accadendo nei pressi di queste strutture.


